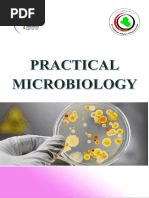

0% found this document useful (0 votes)
111 views44 pagesEssential Microbiology Lab Techniques
This document outlines procedures for several laboratory tests including:
1. Gram stain - used to classify bacteria as gram positive or negative based on cell wall structure and staining properties.
2. Acid-fast bacilli (AFB) stain - used to identify Mycobacteria by staining their lipid-rich cell walls.
3. KOH preparation - used to visualize fungal elements by clearing tissues in specimens using potassium hydroxide solution.
4. Tzanck smear - examines scrapings from vesicle bases for herpes virus or other infections by staining cells.
5. Malaria smear - examines blood films for malaria parasites after staining. Detailed steps and examples are provided
Uploaded by
Jinnasit TeeCopyright
© © All Rights Reserved
We take content rights seriously. If you suspect this is your content, claim it here.
Available Formats
Download as PPTX, PDF, TXT or read online on Scribd
0% found this document useful (0 votes)
111 views44 pagesEssential Microbiology Lab Techniques
This document outlines procedures for several laboratory tests including:
1. Gram stain - used to classify bacteria as gram positive or negative based on cell wall structure and staining properties.
2. Acid-fast bacilli (AFB) stain - used to identify Mycobacteria by staining their lipid-rich cell walls.
3. KOH preparation - used to visualize fungal elements by clearing tissues in specimens using potassium hydroxide solution.
4. Tzanck smear - examines scrapings from vesicle bases for herpes virus or other infections by staining cells.
5. Malaria smear - examines blood films for malaria parasites after staining. Detailed steps and examples are provided
Uploaded by
Jinnasit TeeCopyright
© © All Rights Reserved
We take content rights seriously. If you suspect this is your content, claim it here.
Available Formats
Download as PPTX, PDF, TXT or read online on Scribd